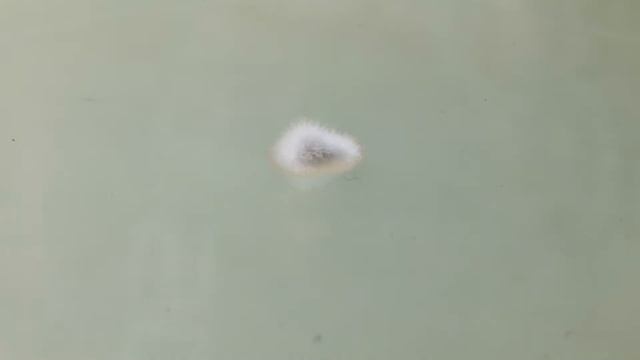
Penicillium vulpinum Timelapse

Будни Майнера. Что будет если перепутать полярность на видеокарте?

Видео
Ссылка на 1Inch
Сайт с кейсами от Техбит -
Будни Майнера.
Что будет если перепутать полярность на видеокарте?
Насчет обмена в Тбилиси в Грузии пишите нам в телеграм Leo_ber или tigdav2004
Телеграм канал Все новости тут
Пул Езил
Или используйте промокод cryptoleo и получайте кэшбек
Крипта Биржи тут:
CEX
BINANCE 20 кешбек навсегда
1Inch
ОБОРУДОВАНИЕ покупаю тут
Видеокарты
Холодные кошельки Ledger
Холодные кошельки Trezor
Промо код на 5 евро FWOSNG8
МОИ КОНТАКТЫ
Телеграм канал или cryptolevan
Телеграм чат или levanber
МОЙ ВЛОГ
Instagram: tbilishvili
Мой Телеграм leo_ber
По Вину пишите Сюда
Купля продажа карт тут
OC ДЛЯ МАЙНИНГА.
ЛИНКИ С ПЛЮШКАМИ
RaveOS
Hive OS в подарок 10 промокод: CRYPTOLEO
Источник: rutube.ru
Похожее видео
⇒Расскажите об этом видео Будни Майнера. Что будет если перепутать полярность на видеокарте?, своим друзьям в социальных сетях.
Ссылка на страницу с видео:
HTML-ссылка на страницу с видео:
Код для вставки плеера:ОЛЕГ ДАЛЬ И ЖАННА АСТЕР - Есть только миг - онлайн
Прикол в ігрі FIFA mobail 2018 ps sv ... - онлайн
Багровый Фантомас - Кубическая страсть (Music Video) - онлайн
Гадалка. 186 выпуск. Ненасытный, - онлайн
Отзыв о компании Корона ремонта квартир от клиента из Москвы-Корона...
 Канал:
Канал: